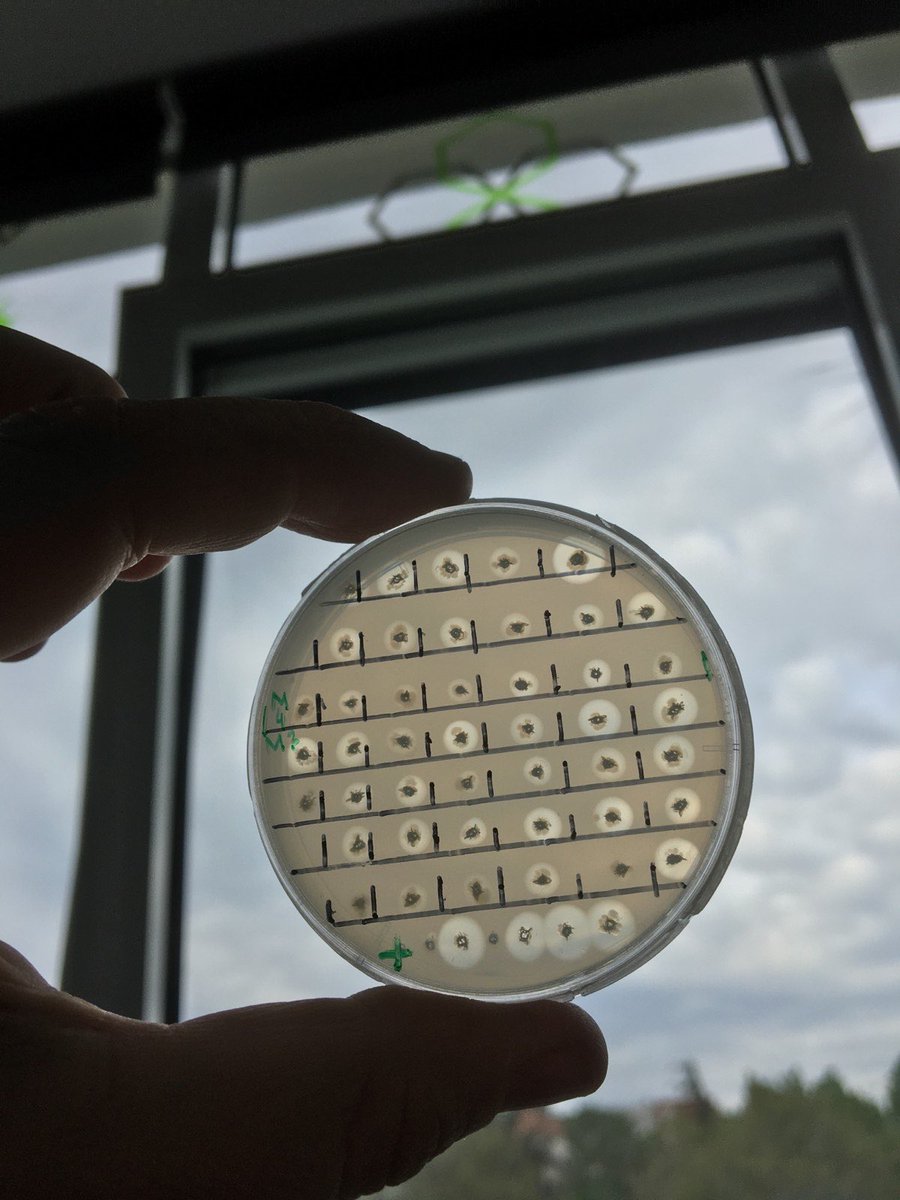
🥳 Directed evolution of depolymerases for more efficient plastic degradation.
Done by <a href="/Marija__N/">Marija Nenadović</a>.

BioICEP_IMGGE
@bioicep_imgge
A team of molecular biologists and chemists developing biotechnological routes for plastic waste degradation and conversion into value-added materials @EU_H2020
ID: 1218159454434275328
https://cordis.europa.eu/project/id/870292 17-01-2020 13:14:02
120 Tweet
135 Followers
81 Following



Pleased to announce that on Friday (07.10) at 14.15 h JasminaNR will talk about microbial approaches in the treatment of plastic laboratory waste as invited speaker during the European Society of Veterinary Clinical Pathology congress meeting in Belgrade. esvcp-belgrade.rs/wp-content/upl…

United colours of Pseudomonas aeruginosa tailor made biofilms vs. PLA, PE and PET 🤩 Ivana Aleksic @jijzarco miplacebio



Something fresh from our Lab! Great collaboration with our dear colleagues from Evangelos Topakas and Maciej Guzik’s labs through Horizon Europe 🇪🇺 funding. #H2020 mdpi.com/2073-4344/13/2…


New paper published by our partners from Chemeng NTUA and BioICEP_IMGGE A huge contribution to find new technologies to fight plastic pollution, consisting of a screening of various fungi for their ability to degrade intact polymers. Learn more here 👇🏻 sciencedirect.com/science/articl…


🥳 Directed evolution of depolymerases for more efficient plastic degradation. Done by Marija Nenadović.